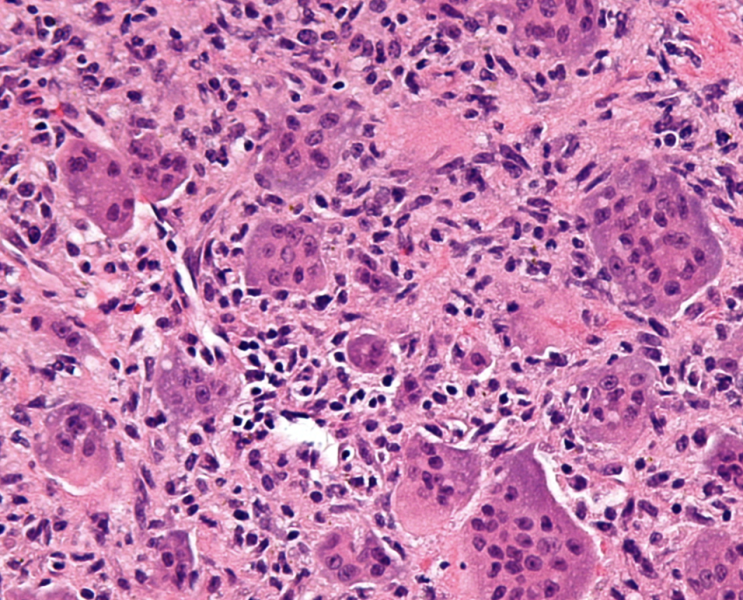

Neutrophil extracellular traps (NET) : 호중구의 자기 희생
2025.03.09

우리 몸에 외부 물질이 침투하여 급성 염증 반응이 일어나면 호중구(neutrophil)는 신속하게 "자기 몸...
출처
https://blog.naver.com/verslanature/223757688731
이슈모어 핫이슈
관련 포스팅
Copyright blog.dowoo.me All right reserved.